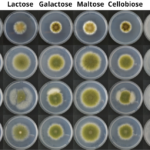
Divulgação - Fungos crescendo em diferentes substratos em placas de Petri.

Fungos deverão ser importante fonte de proteína no futuro
Micoproteínas (proteínas oriundas de fungos) podem oferecer alto valor nutricional e textura semelhante à carne. A produção de micoproteínas pode exigir menos terra e água e emite menos gases de efeito estufa do que a produção animal. Avanços em engenharia genética e fermentação de precisão impulsionam a produção de micoproteínas como...
Melhoramento genético impulsiona criação da “ovelha do futuro”
Pesquisas já resultaram em ovelhas com melhor conformação e rendimento de carcaça, perda espontânea de lã, maior prolificidade e resistência à verminose. Esses animais já foram testados com sucesso na Embrapa Pecuária Sul (RS) e agora seguem para validação em rebanhos comerciais. A expectativa é duplicar a eficácia produtiva na ovinocultura...
Arroba do boi gordo tem nova queda e patamar dos R$ 300 vai ficando para trás
O mercado físico do boi gordo ainda registrou tentativas de compra em patamares mais baixos nesta quarta-feira (24). De acordo com o analista da consultoria Safras & Mercado Fernando Henrique Iglesias, a maior pressão foi sentida em Rondônia e Tocantins.
“Os frigoríficos, em especial os de maior porte, ainda desfrutam de maior conforto em suas...
Suplementação na seca é essencial para a nutrição do gado; entenda
Para que o pasto na seca continue sendo a base da alimentação do rebanho, o planejamento antecipado e a suplementação estratégica são essenciais.
Em entrevista recente ao programa Giro do Boi, o zootecnista Iorrano Cidrini afirmou que, mesmo quando o produtor utiliza o diferimento (vedação) para ter massa disponível, a qualidade da forragem cai...
veja como o mercado abriu a semana
O mercado físico do boi gordo inicia a semana contando com poucas novidades. Segundo o analista de Safras & Mercado Fernando Henrique Iglesias, o ambiente de negócios sugere por alguma alta dos preços no curto prazo, em linha com o bom potencial de demanda previsto em dezembro.
Segundo ele, o mercado interno está em...
Governo do Tocantins e Sudam estudam novos investimentos para o Estado
Sudam quer conhecer potencialidades do Tocantins para viabilizar novos recursos
- Foto: Josy Karla/Governo do Tocantins
O Governo do Tocantins, por intermédio da Agência de Fomento, recebe nesta terça-feira, 29, no Palácio Araguaia, o diretor de Gestão de Fundos e Atração de Investimentos da Superintendência do Desenvolvimento da Amazônia (Sudam), Róger Araújo Castro. Em debate,...
Com abate recorde, boi gordo mantém alta e embarques se encaminham para marca histórica
A arroba do boi gordo foi negociada a uma média de R$ 322,50 na praça-base São Paulo nesta terça-feira (2), conforme o Indicador do Boi Datagro. Este foi o terceiro dia seguido com alta, mesmo cenário encontrado em Minas Gerais, Mato Grosso e Tocantins.
De acordo com a analista de Mercado da consultoria Datagro Beatriz...
Meio Ambiente recebe empresários israelenses que querem investir na piscicultura
Secretária Miyuki Hyashida recebe representantes do Grupo Hadassa, o CEO Jean Petrick Garcia, o sócio Shalom Djoiloski, o diretor Ricardo Magro, o empresário tocantinense Rodolfo Rebouças e o assessor
- Foto: Governo do Tocantins
A pedido do governador do Tocantins, Wanderlei Barbosa, a secretária de Estado do Meio Ambiente e Recursos Hídricos (Semarh), Miyuki Hyashida,...
Decisão da China sobre carne bovina traz alívio ao mercado de boi gordo, diz analista
A decisão da China de adiar por mais dois meses o resultado da investigação sobre as importações de carne bovina trouxe alívio ao mercado pecuário brasileiro. O novo prazo, confirmado pelo Ministério do Comércio do país asiático, estende a análise até 26 de janeiro de 2026.
Segundo o analista da Safras & Mercado, Fernando Henrique...
Brasil está na vanguarda no desenvolvimento de carne cultivada
Projeto inédito da Embrapa tem como objetivo a produção de proteína alternativa (análoga ao peito de frango). Essa tecnologia cria tecidos animais a partir de células animais e vem ganhando força no Brasil e no mundo pelo atual perfil de consumo de alimentos saudáveis. No caso da Embrapa, estão sendo usadas...